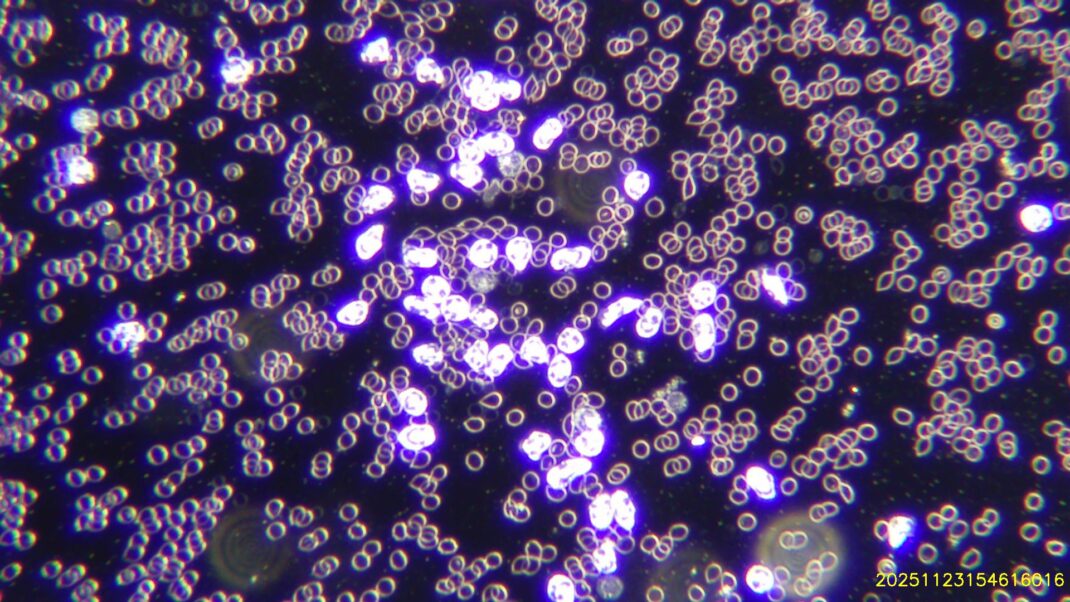

Holistic Nutrition

>What health concerns can a holistic nutritionist help with?
A Holistic Nutritionist addresses health matters such as:
- weight loss
- food allergies and sensitivities
- digestive support
- immune system support
- disease prevention (i.e conditions in your family history)
- reducing inflammation
- lack of energy/fatigue
- detoxification
- chronic stress/ anxiety
- skin health (acne, psoriasis, eczema)
- PMS and hormonal imbalances
>Is there insurance coverage for nutrition consultations?
Consultations with a Registered Holistic Nutritionist are not currently covered by OHIP. However, some extended health care plans do offer coverage. Please check with your provider for more details. Please note that nutrition coverage is different from naturopathic and dietician services.
>Do I need a referral from my family doctor or naturopath?
No referral is needed. If you are actively working with a naturopathic doctor then we can arrange to have your live blood analysis report sent to them for further support in your health care plan.
>Will I receive a custom protocol to take home?
It is important to recognize that every person is biochemically unique and therefore requires an individualized approach. The protocol I provide to clients is tailored to the unique needs of each individual based on live blood analysis results.
>Is it possible to eat healthy on a budget?
Absolutely! Some of the healthiest foods that the earth provides are both affordable and easily accessible. For example: legumes, seasonal fruits/vegetables, whole grains, green leafy vegetables, fresh herbs.
Nutrition recommendations are incorporated into the protocol of every Live Blood Analysis consultation.
Live Blood Analysis
Within one small drop of blood is a vast universe of information regarding your health! Live blood analysis is an extraordinary tool for determining potential weaknesses within the body associated with the state of your red and white blood cells. With the help of a powerful dark field microscope, we can see the unaltered state of your blood and all its components.
>What to expect at your appointment: click here
To start, your practitioner will take a small drop of blood from your fingertip. It will be placed under a high magnification microscope to be examined right before your eyes! During your appointment, you will get to see the live footage of your blood cells while the practitioner reviews and records the findings. A personalized protocol will be created for you based on any concerns and imbalances found in your blood sample.
>Imbalances that can be seen in the blood: click here
Parasitic & bacterial activity
Oxidative damage to the red blood cells
The presence of uric acid crystals
Under active or over active white blood cells
Poorly digested proteins and fats
Poor circulation and oxygen delivery
Malabsorption of nutrients
>How to prepare for your appointment: click here
It is critical that you fast for a minimum of 4 hours before your Live Blood Analysis. You must drink plenty of water. Failure to do so will alter blood results and create an inaccurate reading. Please bring in all natural supplements you are currently using and a list of your prescription medications.
PRICING
Initial Consultation (60 min)- $125 CAD
Follow up (60min)- $85.00 CAD
This is not a diagnostic test but rather an opportunity to be proactive in preventing disease. No referral is necessary for booking.
GALLERY